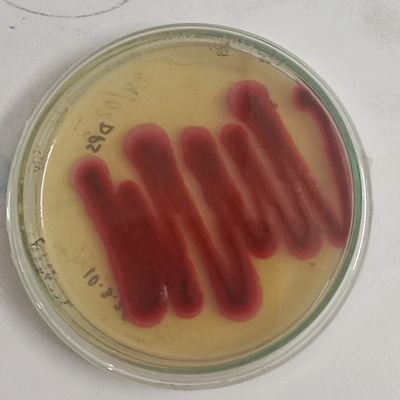
@ShuklaPras61139

SantoshKumarBharatiya
@ABsbps
Followers
1K
Following
148K
Media
3K
Statuses
156K
अखिलभारत🇮🇳 Pan India. सनातनसमताएकता🔆 United Sanatan ll ARWBJPNDZ ll AsVhpRssHmRks स्वयंसेवक ll
भारत India.
Joined August 2022
2 हजार करोड़ की कंपनी 90 करोड़ का क़र्ज़ चुकाने के लिए केवल 50 लाख में बेच दी गई।इतने बड़े घोटाले को आप कैसे जस्टिफ़ाई कर सकते हैं?
29
561
2K
भारत के राष्ट्रगीत वंदे मातरम् के 150 वर्ष पूरे होने पर इस हफ्ते के अंत में संसद के शीतकालीन सत्र में विशेष चर्चा का आयोजन किया जाएगा. लोकसभा में इस पर चर्चा के लिए 10 घंटे का समय निर्धारित किया गया है, जिसमें प्रधानमंत्री नरेंद्र मोदी भी भाग लेंगे. लोकसभा की बिजनेस एडवाइजरी
8
64
596
हिंदवी और रेख़्ता का बेहूदा हिंदू विरोधी एजेंडा हुआ बेनकाब हिंदू देवियों के निजी अंगों के वर्णन वाली फूहड़ कविताओं को अपने प्लेटफ़ॉर्म पर दी जगह रेख़्ता द्वारा चलाए जा रहे इस साहित्यिक जिहाद को समझा रहे हैं @pandeypuraan
14
610
910
कांग्रेस का पतन अनुमानित था | कांग्रेस का पतन लचीला है | यह कल फिर उठेगी | वापस आएगी | लेकिन जब करीब से भाजपा को देखते हैं तो ऐसा महसूस होता है कि भाजपा का जिस दिन पतन होगा , एक झटके में ख़त्म हो जायेगी | उसका कारण है | अगर शुरूआती समय को छोड़ दें, तो कांग्रेस कभी भी एक चेहरे
111
204
1K
The 40 Most Beautiful Countries in the World 1. 🇮🇳 India 2. 🇲🇽 Mexico 3. 🇧🇷 Brazil 4. 🇲🇾 Malaysia 5. 🇨🇳 China 6. 🇦🇺 Australia 7. 🇨🇦 Canada 8. 🇮🇩 Indonesia 9. 🇫🇷 France 10. 🇨🇴 Colombia 11. 🇪🇸 Spain 12. 🇯🇵 Japan 13. 🇿🇦 South Africa 14. 🇹🇭 Thailand 15. 🇮🇹 Italy 16. 🇹🇿 Tanzania 17.
212
34
397
भिलाई टीचर अपहरण कांड : 24 घंटे में सुलझी महिला टीचर के किडनैपिंग की गुत्थी; पैसों के लालच में ऑटो चालक ने ही रची थी साजिश, आरोपी गिरफ्तार जो महिला शिक्षक रोजाना सफर करती है वह थोड़ा सावधानी बरते, किसी भी मुस्लिम ड्राइवर को न रखें और नहीं तो भाईचारा के चक्कर में आपके भी L लग
43
568
1K
"जागो रे हिंदुओं" तेज आवाज में सुबह सुबह भोर को उज्जैन की गलियों में बोलता शब्द अब नहीं गूंज सकेगा दुखद ॐ शांति 💐🙏 उज्जैन में महाकाल के अनन्य भक्त चक्रतीर्थ शमशान में रहने वाले अघोरी बाबा बम बम नाथ कैलाश निवासी हों गए । बाबा महाकाल उन्हें अपने चरणों में स्थान दे। अघोरी
10
55
197
इस प्यार को....क्या नाम दूं? नाजरा नाम की एक मुस्लिम महिला ने आर्य समाज मंदिर में हिंदू धर्म स्वीकार करके अपना नाम नेहा रख लिया और आकाश कुशवाहा नाम के युवक को प्रेमजाल में फंसा कर उससे से लव मैरेज कर ली। 15 दिनों तक वह अपने पति को मुस्लिम बनाने के लिए ब्रेनवाश करती रही जब उसके
12
78
197
One Babri demolished And their community Never votes BJP again. But 3 lakh temples destroyed 10,000 monasteries erased 10 crore Hindus slaughtered 500 universities burned 800 years of devastation Yet today 40% cowardly, greedy, secular Hindus Still side with Islamic Congress.
132
2K
6K
जो आदमी न्यायालय की कस्टडी में रखी सीडी ग़ायब कर के बदलवा सकता हो, वह किसी से क्यों डरेगा। प्रश्न अब @narendramodi सरकार से है कि यह कार्यवाही का छद्म कब तक चलेगा? क्या राहुल गांधी के अलावा कोई सामान्य नागरिक 'गलती' से अपनी नागरिकता व्यापार के कानूनी कागज़ों में ब्रिटिश लिखा कर
आप मेरे खिलाफ 25 FIR दर्ज कर सकते हैं, मैं बीजेपी और RSS के सामने झुक��े वाला नहीं हूं। मैं किसी से नहीं डरता। :- राहुल गांधी
36
490
1K
हाथरस- हर्ष छिकारा ने राम मंदिर को लेकर फैलाई अफवाह, वीडियो देखकर हिंदूवादी संगठनों में भारी नाराजगी, हरियाणा का सोशल मीडिया इनफ्लुएंसर हर्ष छिकारा, राष्ट्र स्वाभिमान दल ने कोतवाली में दी तहरीर #Hathras #RamMandirControversy | @hathraspolice
10
139
292
चेलेंज 🖐️ तू बच के दिखा इस बार...... छि:कारा तेरे जूते न घिसवा दिए हाथरस कोर्ट में तो नाम दीपक नहीं मेरा 🖐️
हाथरस- हर्ष छिकारा ने राम मंदिर को लेकर फैलाई अफवाह, वीडियो देखकर हिंदूवादी संगठनों में भारी नाराजगी, हरियाणा का सोशल मीडिया इनफ्लुएंसर हर्ष छिकारा, राष्ट्र स्वाभिमान दल ने कोतवाली में दी तहरीर #Hathras #RamMandirControversy | @hathraspolice
66
1K
2K
जो किसी से द्वेष-घृणा नहीं करता। जो किसी को शत्रु नहीं मानता, पराया नहीं मानता। जो पूरी वसुधा को अपना कुटुम्ब मानकर मेरा-उसका करने वाली छोटी चेतना (लघु चेतसाम्) से नहीं देखता।
@RahulDev718370 Saccha Hindu kaun hota hai rahul?
51
8
43
सुप्रीम कोर्ट पर विवादित टिप्पणी के सवाल पर बीच इंटरव्यू से भागे महमूद मदनी #Mahmoodmadani | @sucherita_k
26
189
272
महमूद मदनी का सच सामने आ गया! - बोले: “जब-जब जुल्म होगा, तब-तब जिहाद होगा” - वंदे मातरम को ठुकराया - सुप्रीम कोर्ट को गुलाम बताया सुचरिता @sucherita_k के 3 सवाल नहीं झेल पाए, interview छोड़कर भाग गए! इसी जिहादी मानसिकता को SP, कांग्रेस,इत्यादि अपने गले लगाए घूमते
सुप्रीम कोर्ट पर विवादित टिप्पणी के सवाल पर बीच इंटरव्यू से भागे महमूद मदनी #Mahmoodmadani | @sucherita_k
49
577
1K
Mathematics is the language in which God has written the universe. - Galileo Galilei (1564 - 1642)
209
933
5K
India may become the third largest economy by 2029, overtaking Japan and Germany. Top 15 economies of the world: 1. USA 🇺🇸 2. China 🇨🇳 3. Germany 🇩🇪 4. Japan 🇯🇵 5. India 🇮🇳 6. UK 🇬🇧 7. France 🇫🇷 8. Italy 🇮🇹 9. Russia 🇷🇺 10. Canada 🇨🇦 11. Brazil 🇧🇷 12. Spain 🇪🇸 13.
110
91
916
@dpsingh1313 नालंदा की छोड़ और सिक्ख धर्म के बारे में बता :- 1. गुरु अर्जुन देव जी की हत्या किस जाहिल ने की थी? 2. गुरु तेगबहादुर जी की हत्या किस जाहिल ने की थी? 3. गुरु गोविन्द सिंह जी की हत्या किस जाहिल ने की थी? 4. साहबजादों को दीवार में जिंदा किस जाहिल ने चुनवाया था? उत्तर दे... 😠😠
3
3
4
@dpsingh1313 क्यों बे खालिस्तानी भिंडी,तुम्हारा तारानाथ तो ये लिख रहा था,जरा पढ़ तो https://t.co/I4DK82srtI
@Gulshanpost @dpsingh1313 जी हाँ, तारानाथ की "History of Buddhism in India" में तुर्क आक्रमणकारियों द्वारा मठों और वि��ारों के विनाश का वर्णन है, जिसमें पुस्तकालयों में आग लगने और ग्रंथों के महीनों तक जलने का उल्लेख मिलता है। हालांकि, यह 17वीं सदी का विवरण है और कुछ इतिहासकार इसे किंवदंती मानते हैं। मुख्य
0
2
2